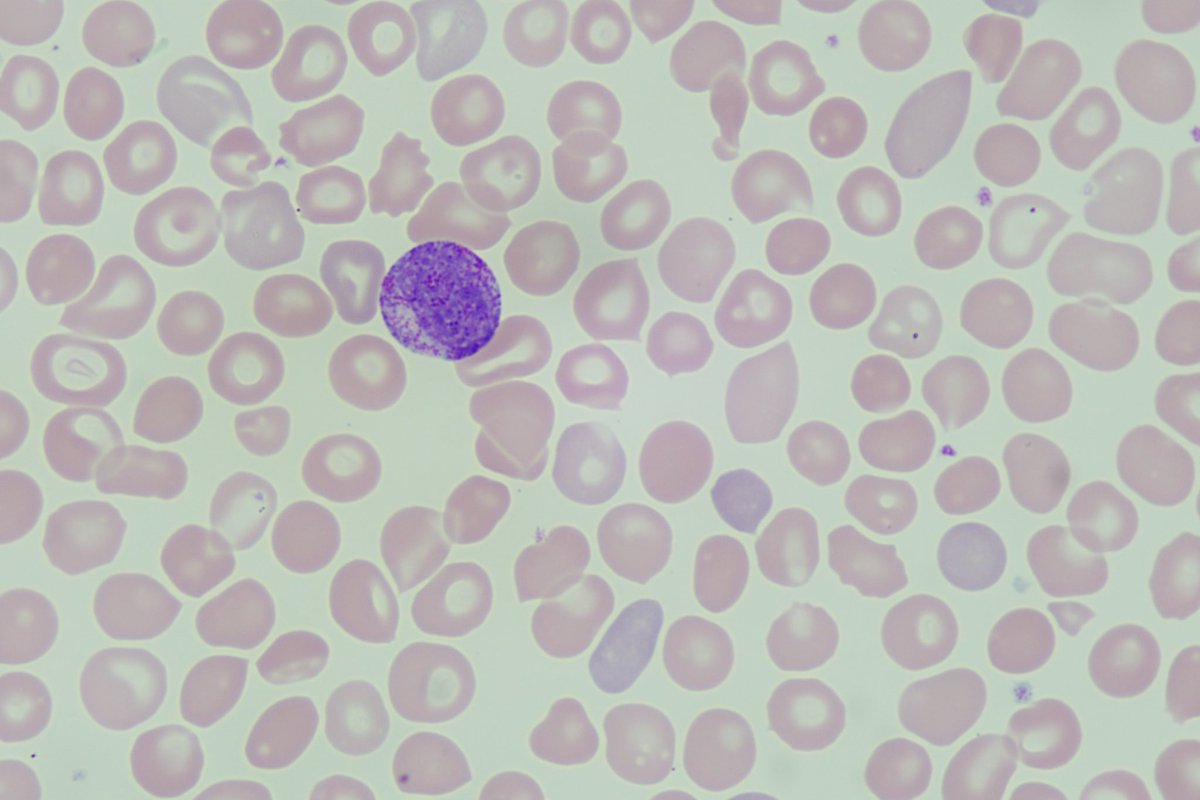
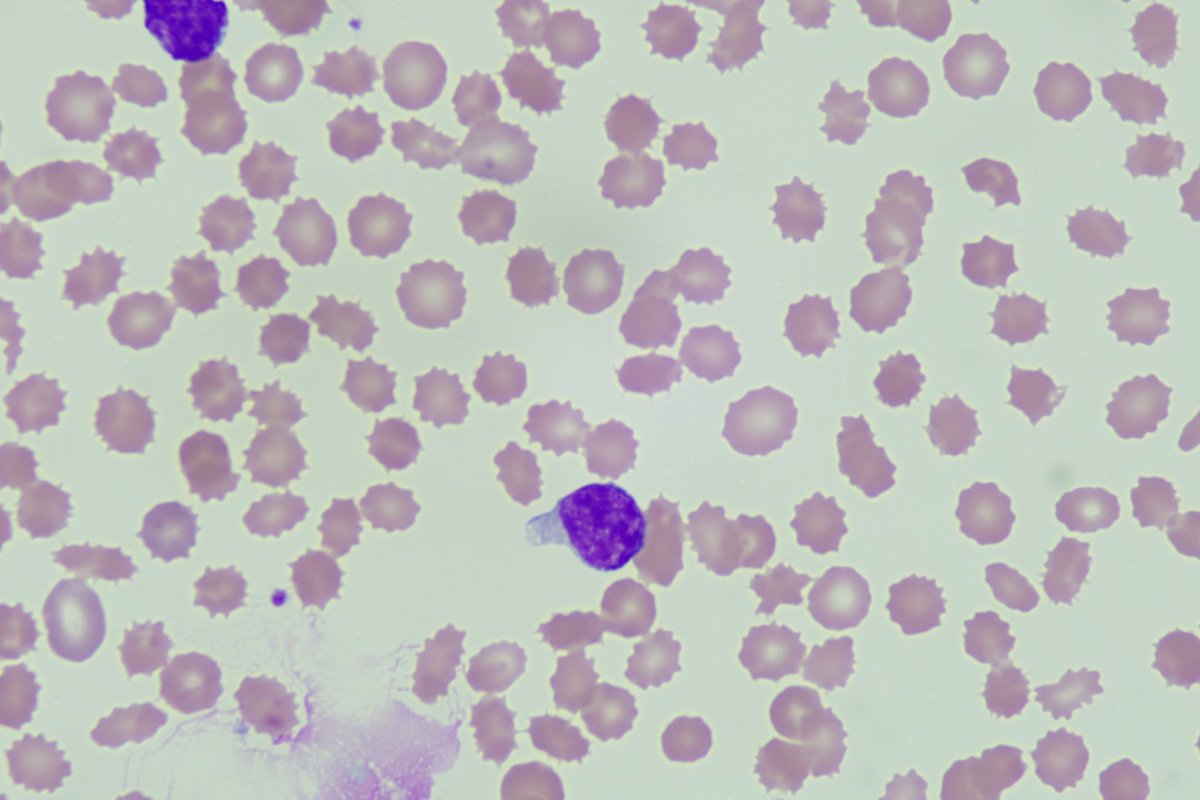
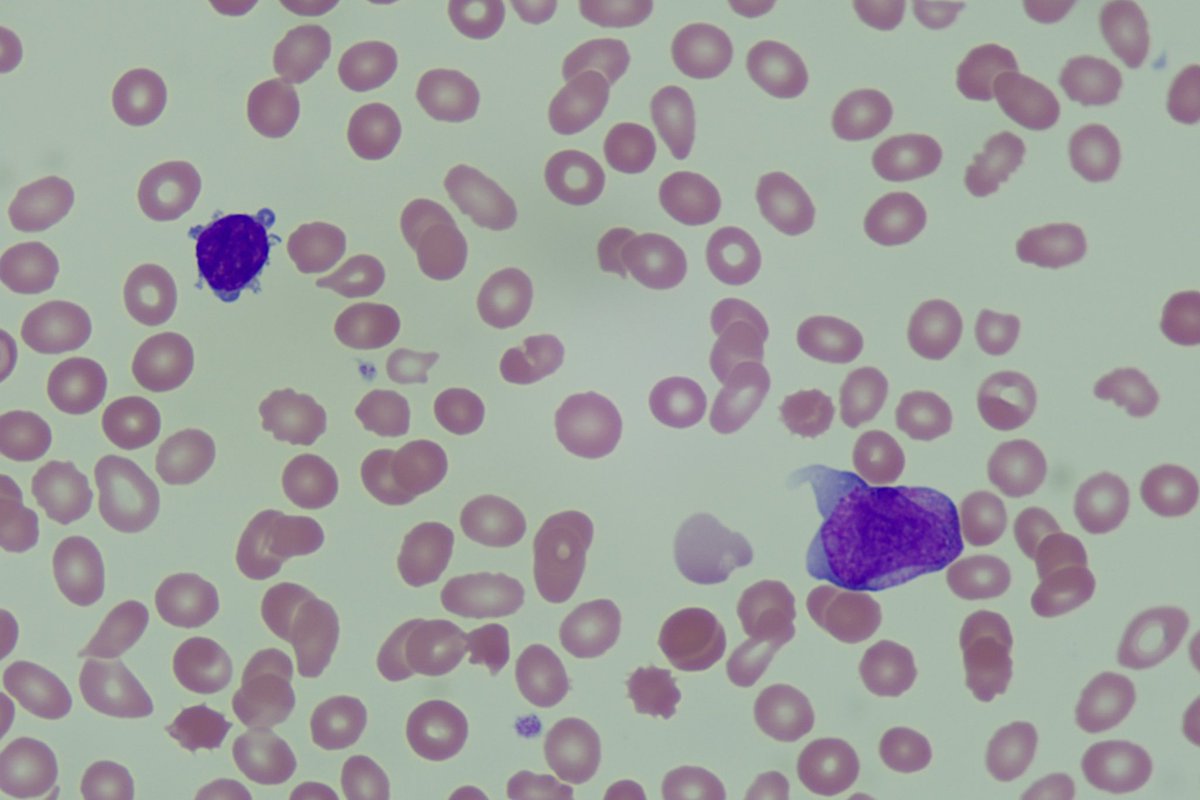
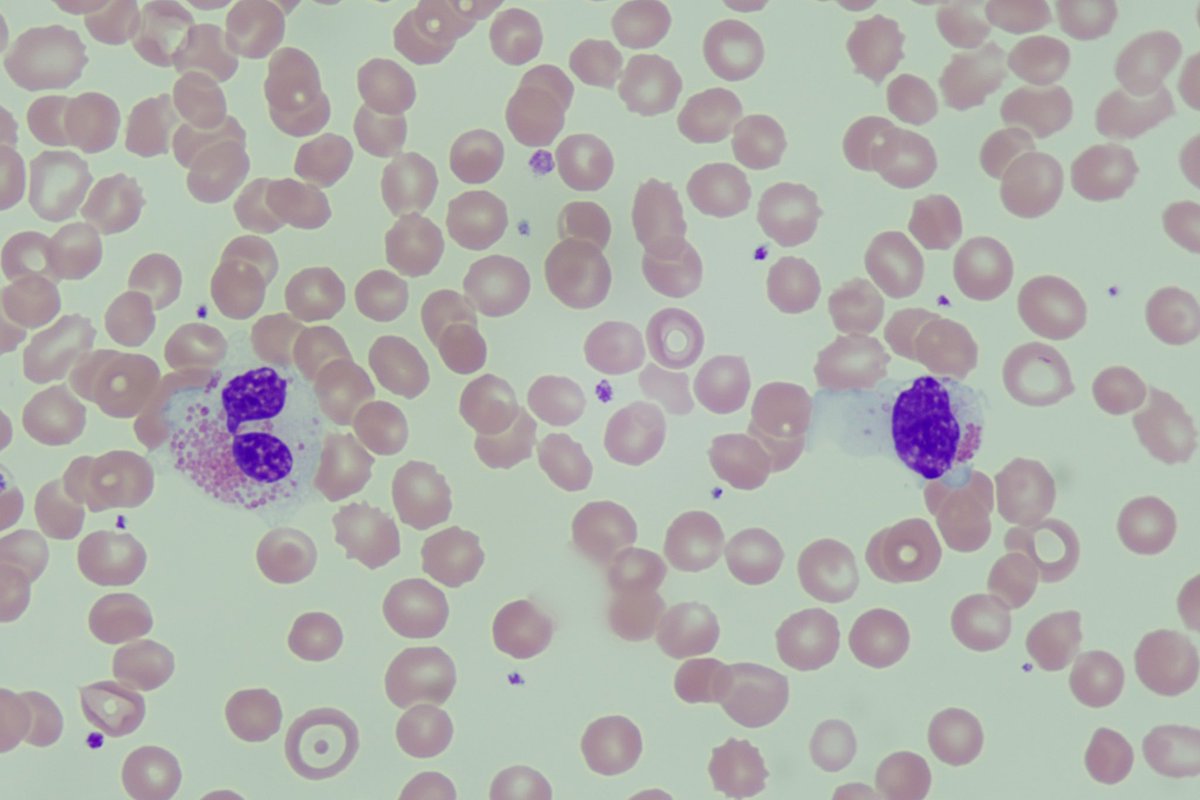
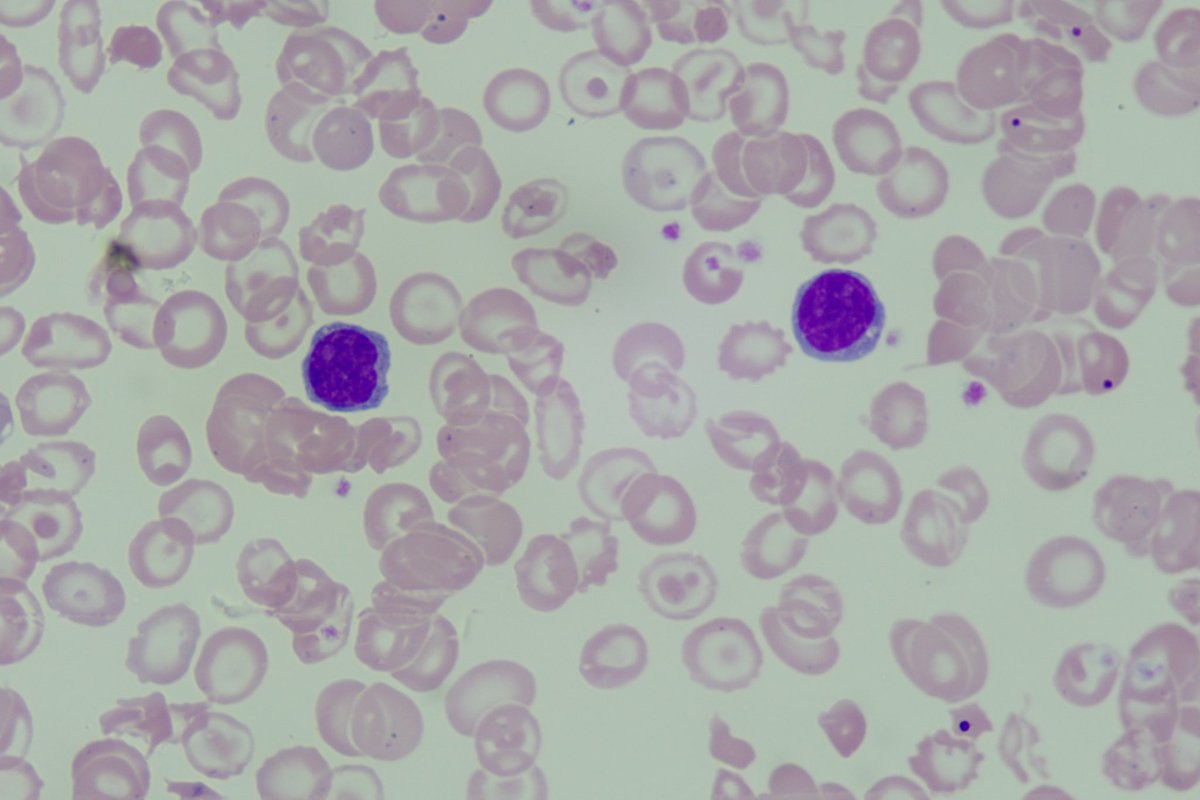
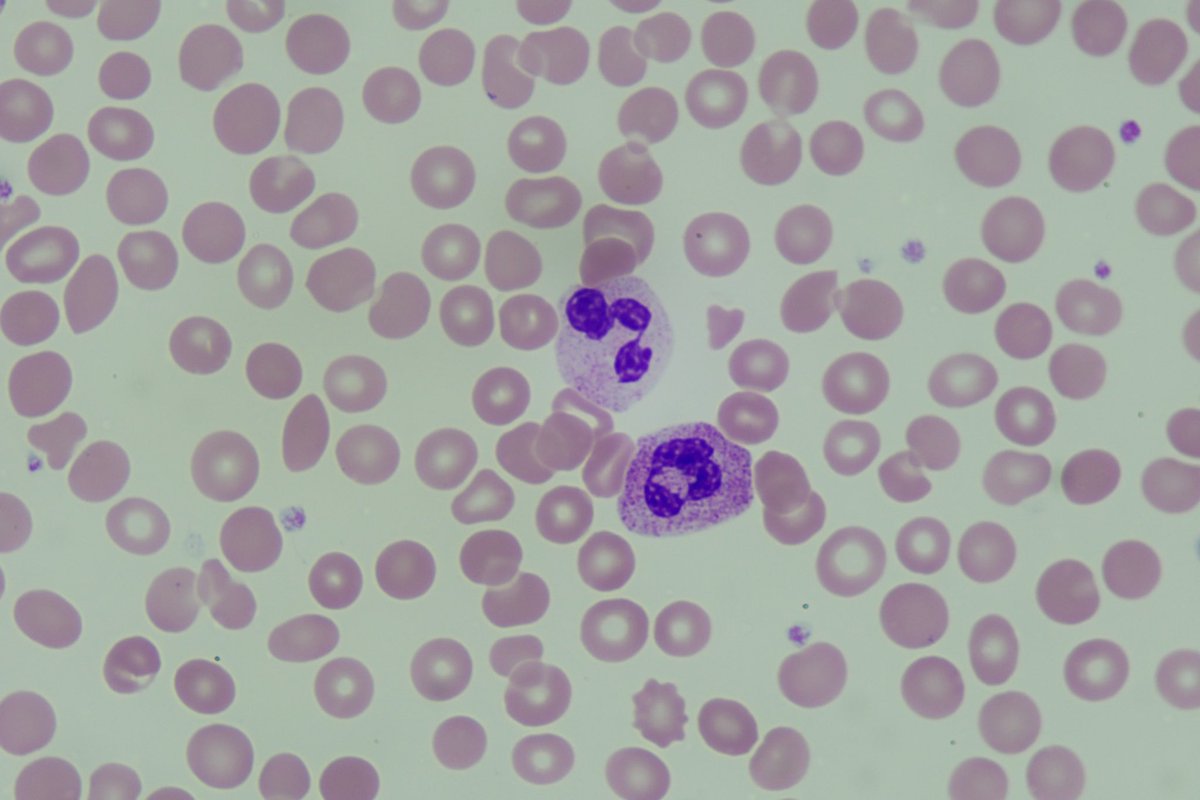
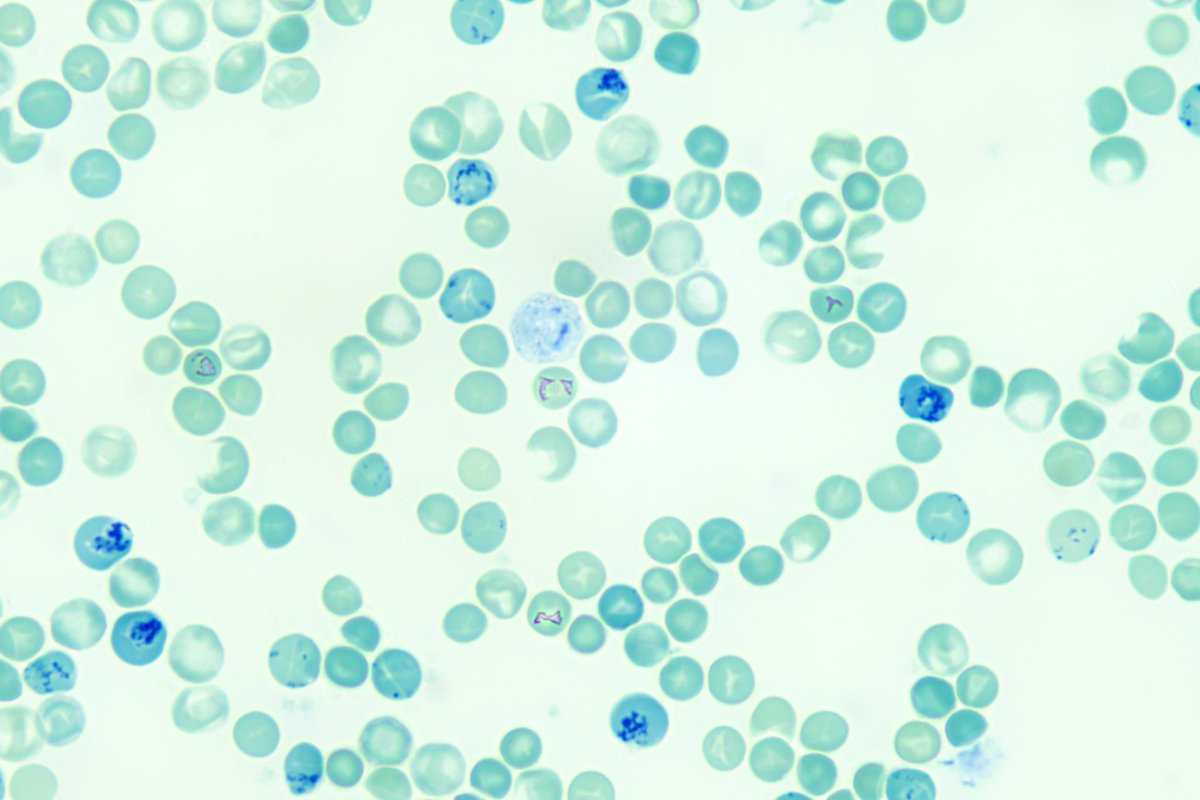

Differential Discussions
@diff_discussion
A couple of medical laboratory scientists talking about cells.
قد يعجبك
We had LaShanta Brice join us twice this month: first to talk about the role of a DCLS and second to review routine coag testing considerations. Here is the link to the DCLS YouTube video youtu.be/-p-XE7YZXXs?si…
youtube.com
YouTube
Guest Series: the Evolving DCLS Role in Industry
Last month we discussed being a PI researcher. This month we will continue on discussing another phase of research: clinical trial management with Ali youtu.be/4yGITJjDAm0
youtube.com
YouTube
Guest Series: Transitioning from the hospital to managing Clinical...
One of the COOLEST things we have done so far, @theclotthickens is back to share some Hemostasis theory by discussing megakaryocytes using some awesome photos and videos youtu.be/RRdBo-VUGeU
youtube.com
YouTube
Theory: Megakaryocytes with Kellie
You asked for it so here it is! A talk on nuclear chromatin patterns of cells on peripheral blood smears youtu.be/lPhXJortnYI

A big thanks to @theclotthickens for joining us to share about her career as a PI rss.com/podcasts/diffe…
Today is a big day - my Podcast debut! I was so excited to be invited on @diff_discussion with @mlser We had a blast (pun intended) talking about what it is like being a PI in a hematology research lab! 🥽🩸🔬 Give it a listen/watch here: youtu.be/qz-aiGWP0D8
youtube.com
YouTube
Guest Series: Research - Principal Investigator
Do That Diff #6 features guest Toula @CastilloToula looking at some interesting cells with us youtu.be/D6T8KcQlBeo

We review another ALL peripheral blood slide, this one has blasts with hand mirror morphology youtu.be/i7vlYq8xUn4

Next we review a slide of Acute Promyelocytic Leukemia (APL) microgranular variant youtu.be/sbJaUTCU05c
An interesting case of ALL that presented with eosinophilia in the peripheral blood but no blasts youtu.be/q0BmSV4pLYY
Do That Diff #5! This one was really interesting with multiple things going on at once youtu.be/geGK7Q-8LaE
Our next video focuses on the effects of G-CSF on the peripheral blood smear youtu.be/8tIHKxoTuNI
Here we look at a new methylene blue stained smear for reticulocytes and discuss manual retic counts youtu.be/UICXNTv4qx4
I don't know who needs to hear this, but...Grades & #USMLE Scores Aren't Everything! Please share this video with a #medstudent (or other student!) who might need a word of encouragement: kikoxp.com/posts/4426 #medtwitter #meded #medstudenttwitter #medicalschool #medschool

United States الاتجاهات
- 1. Chiefs 76.4K posts
- 2. #TNABoundForGlory 39.3K posts
- 3. LaPorta 9,350 posts
- 4. Goff 11.9K posts
- 5. Bryce Miller 3,354 posts
- 6. Kelce 13K posts
- 7. #OnePride 5,618 posts
- 8. Butker 7,874 posts
- 9. #LoveCabin N/A
- 10. #DETvsKC 3,911 posts
- 11. #ALCS 9,176 posts
- 12. Baker 50K posts
- 13. Collinsworth 2,287 posts
- 14. Gibbs 5,253 posts
- 15. Dan Campbell 2,155 posts
- 16. Pacheco 4,458 posts
- 17. Polanco 6,575 posts
- 18. Patrick Mahomes 6,774 posts
- 19. Tyquan Thornton 1,059 posts
- 20. Mike Santana 2,233 posts
قد يعجبك
-
Bread & Butter Haematology
@MorphologyAmigo -
William Aird
@WilliamAird4 -
Blood Cancer Talks
@BloodCancerTalk -
Blood Academy
@blood_academy -
Anas Nasir
@BloodScientist -
@Hemepathguy
@hemepathguy -
Cullen Lilley, MD, MS, MA, MB(ASCP)
@cullen_lilley -
Mikkael A. Sekeres MD, MS
@MikkaelSekeres -
MetroHealth Pathology
@MhPathology -
Annales Bio Clinique
@ABC_JLE -
Medical Lab Lady Gill
@MedicalLabLadyG -
Jake Bledsoe
@jake_bledsoe -
Jeff
@redb56 -
Nicki Close-Lawrence FIBMS CSci
@Promyelocyte13
Something went wrong.
Something went wrong.